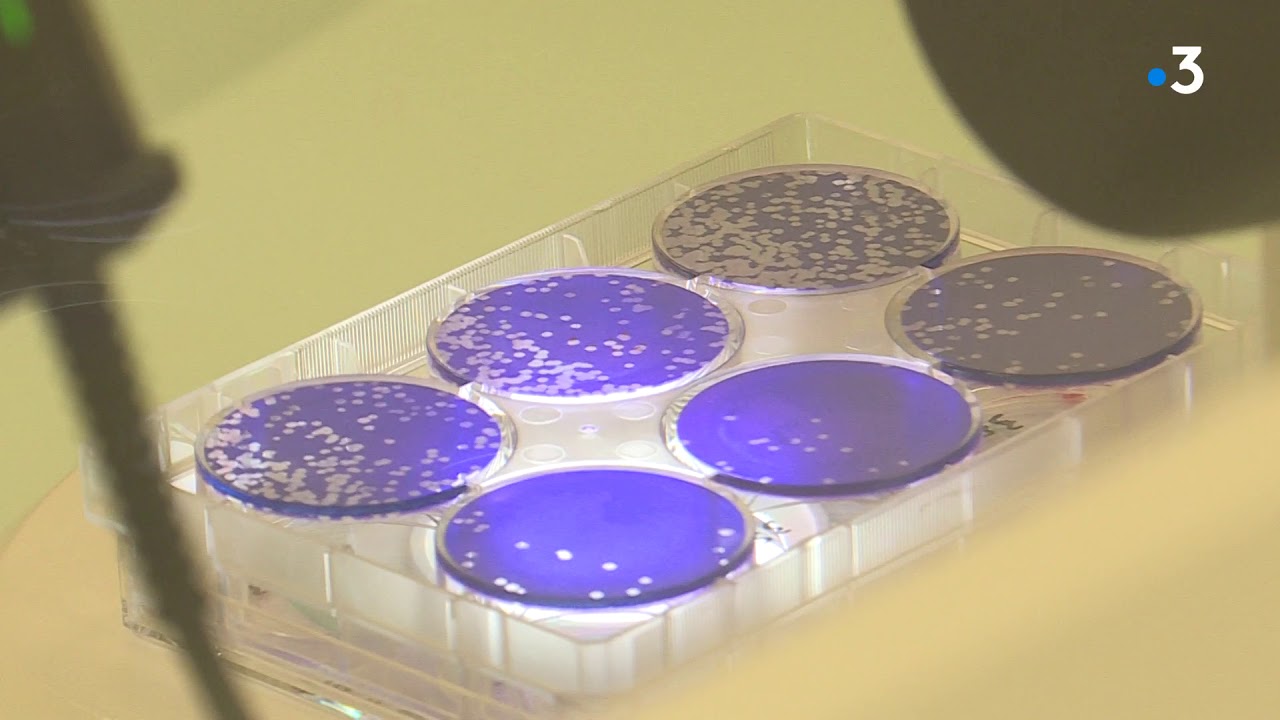
Covid-19 : le laboratoire franco-autrichien Valneva est aussi dans la course au vaccin

WebLa vaccination contre la COVID-19 a pour but principal de réduire les complications, les hospitalisations et les décès liés à la COVID-19. La vaccination pourrait aussi prévenir. WebCentre de Vaccination de Saint-Herblain Adresse : Complexe sportif, Gymnase du Vigneau - Boulevard Salvador Allende 44800 Saint-Herblain Téléphone :. WebLatitude : 47.211344. Longitude : -1.650336. Centre de Vaccinations Covid 19 par département. Saint-Herblain se situe dans le département Loire-atlantique 44.. WebVaccination du coronavirus à SAINT-HERBLAIN. La vaccination en France a débuté le 26 décembre 2020, 1 255 personnes ont reçu la 1ère dose, dont 11 313. WebLes centres de vaccination de Blain, La Baule et le service de santé au travail de la région nantaise (SSTNR) situé à Nantes ferment leurs portes au 30 septembre.
Centre De Vaccination Saint Herblain, Covid-19 : le laboratoire franco-autrichien Valneva est aussi dans la course au vaccin, 2.77 MB, 02:01, 904, France 3 Pays de la Loire, 2021-01-21T17:10:25.000000Z, 3, Coronavirus. Les mesures prises par Saint-Herblain, www.ouest-france.fr, 1260 x 712, jpeg, herblain, 20, centre-de-vaccination-saint-herblain, New Topics
WebTéléphone. 0240651396. Coordonnées GPS Pharmacie Maurellet. Latitude : 47.180353. Longitude : -1.587197. Centre de Vaccinations Covid 19 par département. Bouguenais se. WebCentres de vaccination Pfizer et Moderna* (selon les disponibilités) Les vaccins bivalents de Moderna et Pfizer sont maintenant disponibles en Estrie sur rendez-vous. Prendre. WebLe plan de vaccination risque de se prolonger durablement. Le maire de fait le point, chaque semaine, avec la préfecture pour ajuster l’accompagnement des. WebCentrale de rendez-vous. Téléphone : 450 756-1628 ou 1 888 326-7168. Heures d'ouverture : du lundi au vendredi, de 8 h à 12 h et de 13 h à 16 h. En personne : du lundi au. WebAdresse. 15 Rue de Saint Nazaire, 44800 Saint-Herblain S'y rendre. WebCentre de vaccination - St HERBLAIN - Complexe du Vigneau. Accès uniquement sur rendez-vous; Boulevard Salvador Allende 44800 Saint-Herblain Téléphone : 08 06 00 03. WebLe centre de vaccination, installé au complexe du Vigneau depuis le 29 mars, n’accueille pas, pour le moment, les plus de 55 ans. D’autre part, le vaccin utilisé. Web9 (110 avis) 885 m - 3 rue Jean Monnet, 44800 Saint-Herblain. Très bien 8. A partir de 50 €. Réserver. ibis Nantes Saint Herblain. 8 (714 avis) 1.11 km - 345 boulevard Marcel Paul,. WebRLS de Vallée-de-la-Batiscan. Du 26 juillet au 5 septembre 2022, nous vous invitons à communiquer avec la pharmacie communautaire, le 811, votre médecin de famille ou le. WebLes sites de vaccination en Estrie. Coaticook : 295, rue Saint-Jacques Nord; Cowansville : 175 rue Principale; East Angus : 143, avenue St-Pierre; Granby : Centre.
À propos Covid-19 : le laboratoire franco-autrichien Valneva est aussi dans la course au vaccin tendance
Articles Conseil municipal du 12 avril 2021 mise à jour
Vidéos vaccins à ARN et ADN : la vaccination du futur tendance
Autres descriptions de Centre De Vaccination Saint Herblain
Cette bonne nouvelle pour le laboratoire franco-autrichien Valneva dont le siège est implanté à Saint-Herblain près de Nantes.
Il vient d'annoncer la signature prochaine d'un contrat pour 60 millions de doses de son vaccin avec l'Union Européenne.
Il deviendrait ainsi le 8ème laboratoire dans la campagne vaccinale à l'échelle européenne.
Un vaccin développé avec le soutien financier du Royaume-Uni mais qui est différent des autres. Une autre technologie a été utilisée, l’intérêt c'est qu'il pourra s'adresser à tout type de population comme les femmes enceintes...
Interviennent dans ce reportage :
- Franck Grimaud, directeur général Valneva
Reportage de Marion Naumann, Boris Vioche et Sophie Boismain
Les différents canaux pour nous suivre :
?Orange/Sosh 320 | ?Free 321 | ?SFR/Red et Numéricable 450 | ?Fransat 314 | ?Canal Sat 369 | ?Bouygues/ Bbox 489 | ?Darty Box 311|
Toute l'actualité en Pays de la Loire ?pdl.france3.fr
Facebook ? facebook.com/france3pdl
Twitter ? twitter.com/F3PaysdelaLoire
Instagram ? instagram.com/france3pdl/
Pour ne rien manquer, abonnez-vous à nos newsletters
? francetv.fr/abonnements/
Incontournable Coronavirus. Les mesures prises par Saint-Herblain viral
À propos Pôle Santé Saint-Herblain : les travaux sont lancés populaire
Ouverture du centre de vaccination du Larry | Orléans métropole

Articles Challans. De nouveaux créneaux au centre de vaccination
Sujets Covid-19 : pourquoi n’y a-t-il pas plus de centres de vaccination en viral

À propos Au centre de vaccination de Bierset, les jeunes aux études devenir viral

Images Covid jab vial stolen from Edinburgh vaccination centre - BBC News le plus

Discussion Coronavirus. [Vidéo + diaporama] En emménageant au gymnase tendance
![Centre De Vaccination Saint Herblain Coronavirus. [Vidéo + diaporama] En emménageant au gymnase](https://cdn-s-www.dna.fr/images/1655072B-C188-4488-AB27-378DB6589BCF/NW_raw/anne-laure-21-ans-profite-de-l-ouverture-de-la-vaccination-covid-pour-tous-des-18-ans-le-principal-centre-de-vaccination-de-mulhouse-a-quitte-le-palais-des-sports-pour-s-installer-au-gymnase-universitaire-cela-lui-permet-d-augmenter-sa-capacite-journaliere-photo-l-alsace-darek-szuster-1622563095.jpg)
À propos Orthez : le centre de vaccination Covid de l’hôpital ouvre mardi 19

Sujet Ouverture d'un nouveau centre de vaccination au CCAS - Fêtes de Bayonne

0 Comments